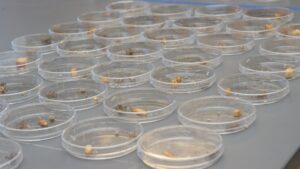

The Complex and Collaborative World of Cancer Research
Few people have not been touched, directly or indirectly, by cancer. That fact has long motivated Evan Davis ’18, Ph.D., to act. As a teenager, Davis participated in the American Cancer Society鈥檚 Relay for Life, raising funds for cancer research, patient support, and advocacy. Today, he is an applied research scientist at the Moffitt Cancer Center in Tampa, Fla., where he focuses on early detection and prevention of pancreatic cancer. His work analyzing data aims to help pancreatic cancer patients live longer, more fulfilling lives, with the ultimate goal of finding a cure.
Few people have not been touched, directly or indirectly, by cancer. That fact has long motivated Evan Davis ’18, Ph.D., to act. As a teenager, Davis participated in the American Cancer Society鈥檚 Relay for Life, raising funds for cancer research, patient support, and advocacy. Today, he is an applied research scientist at the Moffitt Cancer Center in Tampa, Fla., where he focuses on early detection and prevention of pancreatic cancer. His work analyzing data aims to help pancreatic cancer patients live longer, more fulfilling lives, with the ultimate goal of finding a cure.
Davis initially intended to become a medical doctor, but his passion for scientific inquiry led him to research. Studying gene mutations in fruit flies as an undergraduate at Le Moyne deepened his interest. Immersed in the Jesuit ideal of cura personalis鈥攃are for the whole person鈥攈e became interested in how cancer could be prevented and how its burden could be reduced. This led him to pursue a master鈥檚 in public health from SUNY Upstate Medical University and a doctorate in cancer epidemiology from Roswell Park Comprehensive Cancer Center in Buffalo, N.Y..
Davis emphasizes that research requires resilience, as setbacks are common. However, he views challenges as opportunities to “peel back the layers of an onion,” leading to deeper insights.
At the end of the day, my biggest goal is to contribute to research that makes a real difference in people鈥檚 lives.
Research in your field inspires knowledge of yourself and we're here to help.
A Le Moyne education will provide you with the intellectual skills necessary to succeed in the world and the capacity to use your abilities to promote a more just society.


